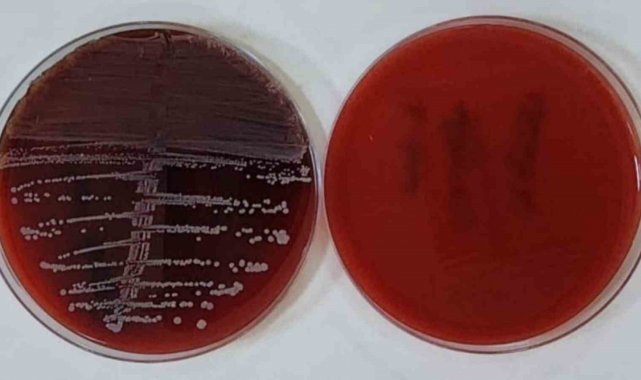

Karabük Üniversitesinde (KBÜ), TÜBİTAK destekli projeyle vücut içine yerleştirilen implantlarda enfeksiyon riskini azaltacak ısıtma temelli yeni bir yöntem geliştirildi.
TÜBİTAK 1005 desteğiyle yürütülen "Vücut İçine İmplante Edilebilen Metal İmplantların İndüksiyon Isıtma Tekniği Kullanılarak Bakterisidal Isı Etkisine Kadar Isıtması" başlıklı proje, tıp alanında sıkça karşılaşılan implant enfeksiyonlarının önlenmesine yönelik önemli bir çalışma olarak öne çıkıyor.
KBÜ Mühendislik ve Doğa Bilimleri Fakültesi Öğretim Üyesi Prof. Dr. Selim Öncü'nün yürütücülüğündeki araştırma ekibinde, Prof. Dr. Tansel Mutlu, Dr. Öğr. Üyesi Şerife Yılmaz Gürbüz ve Eflani Meslek Yüksekokulundan Öğr. Gör. Fatih Akoğlu yer alıyor.
Geliştirilen sistemle implant yüzeyinde oluşan bakterilerin ve biyofilm tabakasının ortadan kaldırılması hedefleniyor.
KBÜ Elektrik-Elektronik Mühendisliği Bölümü Öğretim Üyesi Prof. Dr. Selim Öncü, geliştirdikleri elektronik devre sayesinde, implantın bobine farklı uzaklıklarda da verimli şekilde ısıtılabildiğini vurguladı.
Öncü, sistemin işleyişine ilişkin olarak şu değerlendirmede bulundu:
"Tasarladığımız elektronik devre ile indüksiyon bobinden geçirdiğimiz değişken frekanslı alternatif akım, metal implant üzerinde elektromanyetik indüksiyon yoluyla ısıtma gerçekleştiriyor. Test düzeneğinde implantın bobine olan uzaklığı değiştirilerek farklı mesafelerde ısıtma performansı incelenebilmektedir. Beş farklı bakteri için yaptığımız testlerde, ısıtma öncesi ve ısıtma sonrası aldığımız sonuçların verimli olduğu sonucuna vardık."
Proje fikir ortaklarından araştırmacı Prof. Dr. Tansel Mutlu ise implant kaynaklı enfeksiyonların ortopedi ve travmatoloji başta olmak üzere birçok cerrahi branş için ciddi bir problem olduğunu vurgulayarak, "Proje, protezle ilgili enfeksiyonlara çözüm sağlanabileceğini göstermektedir. İmplantları vücuttan çıkarmadan, ek cerrahi tedavilere ihtiyaç kalmadan etkili çözüm sağlanabileceği anlaşılmaktadır" ifadelerini kullandı.
Çalışmaya katkı sunan KBÜ Tıp Fakültesi Öğretim Üyesi Dr. Şerife Yılmaz Gürbüz de implant enfeksiyonlarının ortopedi alanında en sık karşılaşılan ve tedavisi güç hastalıklar arasında yer aldığını belirterek, "İmplantı bakterilerle enfekte ettikten sonra hazırladığımız sistemle bir hafta bekletip indüksiyon ısıtma uyguladık. Kontrollerde bakterilerin üremesinin azaldığını, bazı türlerde ise tamamen kaybolduğunu gözlemledik" diye konuştu.
Kültür-Sanat
Yayınlanma: 23 Ekim 2025 - 15:08
Güncelleme: 23 Ekim 2025 - 16:10
KBÜ'den implant enfeksiyonlarına karşı yenilikçi yöntem
Kültür-Sanat
23 Ekim 2025 - 15:08
Güncelleme: 23 Ekim 2025 - 16:10
Karabük Üniversitesinde (KBÜ), TÜBİTAK destekli projeyle vücut içine yerleştirilen implantlarda enfeksiyon riskini azaltacak ısıtma temelli yeni bir yöntem geliştirildi.
EDİTÖR

Haberler İHA Haber Ajansı tarafından sağlanmaktadır.
İlginizi Çekebilir